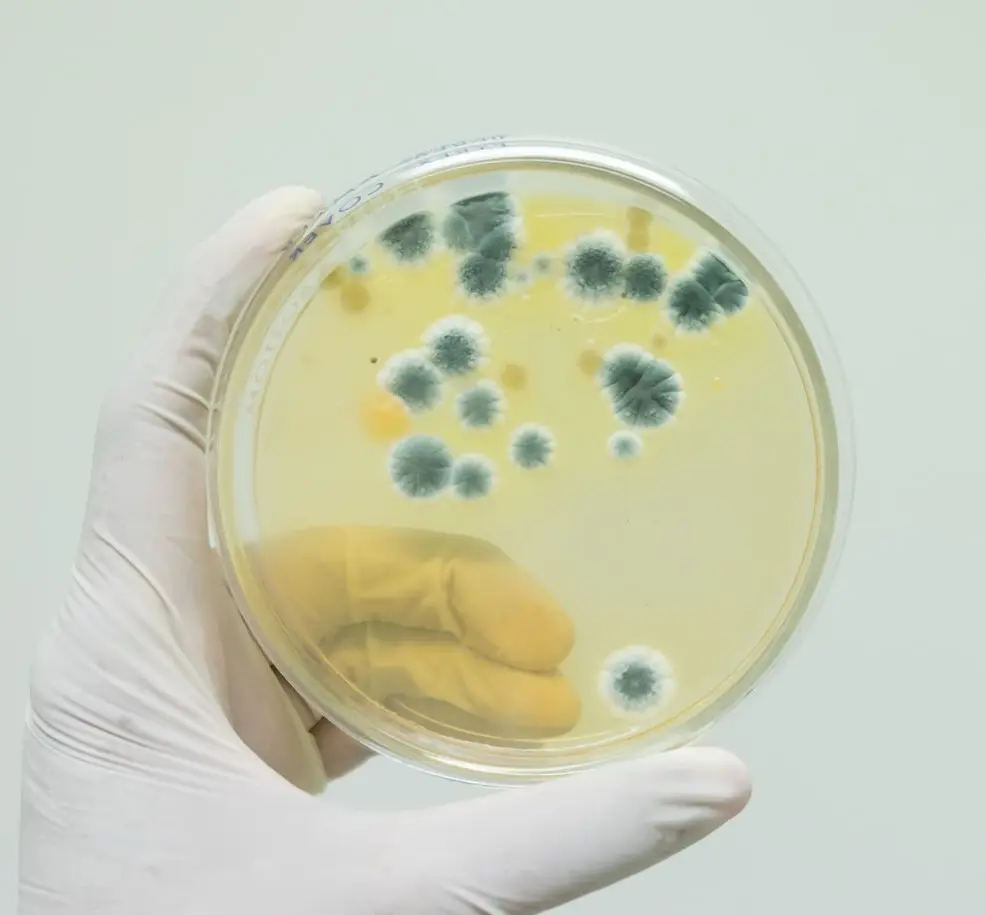

Eurofung
Eurofung is a project funded by EC, and is aiming to explore and enlarge the possibilties of filamentous fungi as cellfactories.


European Collaboration
The Eurofung research programme is carried out by 28 European laboratories, both academic (21) and industrial (7), which are all highly qualified.
They belong to 9 different countries. A Fungal Industrial Platform of 17 members is associated with the programme to exploit the results and to stimulate commercial activities as a consequence.
Gentaur Fungus and Yeast Elisa detection kits
- 3 Elisas 5% discout
- 5 Elisa kits 10 % discount
- 10 Elisa test kits 15 % discount
Available for next week delivery in the USA and Europe:
- DNK-1401-1 Dynamiker Fungus (1-3)-β-D-Glucan Assay 96 TESTS/KIT €800.00
- DNK-1402-1 Dynamiker Aspergillus Galactomannan Assay (ELISA) 96 TESTS/KIT €600.00
- DNK-1403-1 Dynamiker Candida Mannan Assay (ELISA) 96 TESTS/KIT €560.00
- DNK-1407-1 Dynamiker Aspergillus fumigatus IgG Assay (ELISA) 96 TESTS/KIT €450.00
- DNK-1409-1 Dynamiker Candida albicans IgG Assay (ELISA) 96 TESTS/KIT €400.00
- DNK-1411-1 Dynamiker Cryptococcal Antigen Lateral Flow Assay(LFA) 40 TESTS/KIT €320.00
- FIC-Q100N Fluorescent Immunoanalyzer 1 PC €1000
- DNK-1414-1 QuicGMTM Aspergillus Galactomannan Ag Lateral Flow Assay 50 TESTS/KIT €480.00
- DNK-1415-1 QuicIgGTM Aspergillus IgG Ab Lateral Flow Assay 50 TESTS/KIT €480.00
- DNK-1416-1 MycoMDx Aspergillus PCR Assay 50 TESTS/KIT €700.00
- DNK-1417-1 MycoMDx Candida PCR Assay 50 TESTS/KIT €700.00
- DNK-2107-1 MycoMDx Candida auris PCR Assay 50 TESTS/KIT €700.00
- DNK-2108-1 MycoMDx Mucor PCR Assay 50 TESTS/KIT €700.00
- DNK-2109-1 MycoMDx Pneumocystis jeroveci PCR Assay 50 TESTS/KIT €700.00
- DNK-2110-1 MycoMDx Talaromyces marneffei PCR Assay 50 TESTS/KIT €700.00
- DNK-2302-1 Carbapenem Resistant Enterobacteriaceae Test Kit (LFA) 40 TESTS/KIT €460.00

Research Topics
1. The Secretion Process
The first research topic deals with the production of heterologous proteins. Filamentous fungi are able to secrete proteins in large quantities. However, the yield of heterologous proteins is often low. A major bottleneck is the inefficient folding of foreign proteins in the endoplasmatic reticulum, leading to unfolded protein response and stress. A comprehensive understanding of the cellular reactions involved is necessary to identify essential factors. These factors can be genetically engineered and tested in production systems.

2. Enzyme Production
The second research topic focuses on two aspects of the production of enzymes, viz. production rate and substrate utilization. In order to increase the fungal production rate, the complex structure of the central metabolism, which delivers the building blocks for protein biosynthesis, requires research on regulation of gene expression, sugar metabolism and the quantification of the relative fluxes through various pathways. Based on these results the fungal strains can be improved by genetic engineering. As for the second aspect, improving substrate utilization is done by focusing on the use of low price waste products as a substrate, such as hemicellulose, which is a by-product of the agro-industry.

3. Novel Peptides
The third topic deals with the discovery and design of novel non-ribosomal peptides, which are identified by novel screening methods or made by combinatorial approaches and screened for their bio-activity. Novel peptide biosynthesis will be integrated into a fungal cell factory and optimized for a high flux through the metabolic pathway process. This gives fungal researchers the opportunity to meet the urgent need for new antibiotics to fight increased bacterial resistance.

EUROFUNG FOCUSES ON MEDICAL RESEARCH IN THE EU SIXTH FRAMEWORK PROGRAMME
Unlock the potential of filamentous fungi, nature's remarkable cell factories. These versatile microorganisms are at the forefront of biotechnology, enabling sustainable solutions for industrial challenges.
Our mission is to explore and expand the possibilities of filamentous fungi, leveraging their unique abilities for the production of enzymes, bioactive compounds, and valuable biomaterials. From pharmaceuticals to biofuels, these organisms hold the key to innovation in diverse fields.
Why Filamentous Fungi?
Diversity:
A vast genetic and metabolic toolkit ready for engineering and optimization.

Scalability:
Easily adaptable for industrial-scale production processes.

Sustainability:
Efficient bioconversion of renewable raw materials into high-value products.

Natural Producers:
Known for their ability to produce a wide array of secondary metabolites and enzymes.
Characteristics and Classification of Fungi
Fungi are a diverse kingdom of eukaryotic organisms distinct from plants, animals, and bacteria. They are characterized by their chitin-rich cell walls, heterotrophic nutrition, and unique modes of reproduction. Unlike photosynthetic plants, fungi obtain nutrients by decomposing organic matter (saprophytic), forming mutualistic relationships (mycorrhizal), or parasitizing other organisms. Morphologically, fungi range from unicellular forms like yeasts to multicellular filamentous forms such as molds, with a network of hyphae collectively forming a mycelium. Reproduction occurs through spores, which can be produced sexually or asexually depending on the species and environmental conditions.
Fungi are classified into major groups based on their reproductive structures and genetic relationships:
Zygomycota: Produce zygospores and include molds like Rhizopus.
Basidiomycota: Club fungi with spores produced on basidia, including mushrooms and rusts.
Ascomycota: Known as sac fungi, they form spores in sac-like asci and include yeasts, molds, and morels.
Chytridiomycota: Primitive fungi with flagellated spores, often found in aquatic environments.
Glomeromycota: Symbiotic fungi forming arbuscular mycorrhizal associations with plant roots.